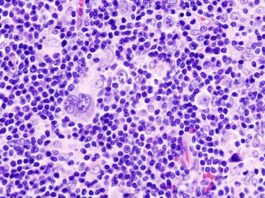
Major Improvements In Treating Hodgkin’s Lymphoma

RECENT ARTICLES
Major Improvements In Treating Hodgkin’s Lymphoma
Now, Hodgkin lymphoma is considered one of the most curable cancers due to rapid and successful advancements in treatments and diagnosis.
Mind Over Matter: The Placebo Effect In Healing
The awesome technology of modern medicine casts an image of such great potency and knowledge that it is hard to believe our individual resources can make much difference to the healing process. Here's a documented anecdote that says otherwise!
Anita Moorjani’s ‘Out-of-Body’ Experience & Spontaneous Remission
Anita Moorjani's amazing experience shows us that spontaneous remissions from cancer can and do occur, even though no one knows exactly how!
Cancer Can Be Funny!
Without trivialising cancer, can we see the humour in it? Here are a few 'ticklers'!
How Spirituality Helped A Non Hodgkins Lymphoma Thriver Heal
The best way to come out of sorrow is to go through it- a beautiful concept of Sri Mumtaz Ali that has stuck with Mr. Sunshine. It is advice that we can all benefit from.
What Causes Leukemia & Lymphoma: Mental & Emotional Triggers To Consider
Diving into some deeper issues and questions about why blood cancers arise.